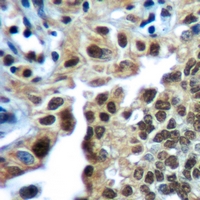

RB1 Rabbit Monoclonal Antibody(ARA831)
CAT.NO. : ARA6642
RMB Please choose
RMB Please choose
Size:
Trail, Bulk size or Custom requests Please contact us
*产品价格可能会有所调整,请以品牌方官网实时更新的价格为准,以确保准确性。
Background
Rb is a tumor suppressor nuclear phosphoprotein capable of binding to DNA. It is phosphorylated on serine and threonine, but not on tyrosine residues. It forms a complex with SV40 large T antigen, adenovirus E1A, and human papilloma virus-16 E. Rb protein may act by regulating transcription and loss of its function leads to uncontrolled cell growth. Aberrations in the RB gene have been implicated in cancers of breast, colon, prostate, kidney, nasopharynx, and leukemia.
Application
| Application | Dilution Ratio |
|---|---|
| WB | 1:500 - 1:1000 |
| IHC | 1:50 - 1:200 |
Overview
| Product Description | Recombinant rabbit monoclonal antibody to RB1 |
| Immunogen | Recombinant fusion protein of human RB1. The exact sequence is proprietary. |
| Purification Method | The antibody was purified by immunogen affinity chromatography. |
| Clonality | Monoclonal |
| Product Form | Liquid in PBS, pH 7.3, 50% glycerol, and 0.05% Proclin300. |
| Gene Name | RB1 |
| Related Names | Retinoblastoma - associated protein; p105 - Rb; pRb; Rb; pp110 |
| Gene ID (Human) | 5925 |
| Gene ID (Mouse) | 19645 |
| Gene ID (Rat) | 24708 |
| Protein ID (Human) | P06400 |
| Protein ID (Mouse) | P13405 |
| Protein ID (Rat) | P33568 |
Data

Western blot analysis of RB1 expression in A431 (A), H1792 (B), A2780 (C) whole cell lysates. (Predicted band size: 106 kD; Observed band size: 110 kD)
Immunohistochemical analysis of RB1 staining in human lung cancer formalin fixed paraffin embedded tissue section. The section was pre-treated using heat mediated antigen retrieval with sodium citrate buffer (pH 6.0). The section was then incubated with the antibody at room temperature and detected using an HRP conjugated compact polymer system. DAB was used as the chromogen. The section was then counterstained with haematoxylin and mounted with DPX.
Storage
Store at 4°C short term. For long term storage, store at -20°C, avoiding freeze/thaw cycles.
Research Use Only
For Research Use Only. Not for use in diagnostic procedures.
New Products
Protocol Booklet
